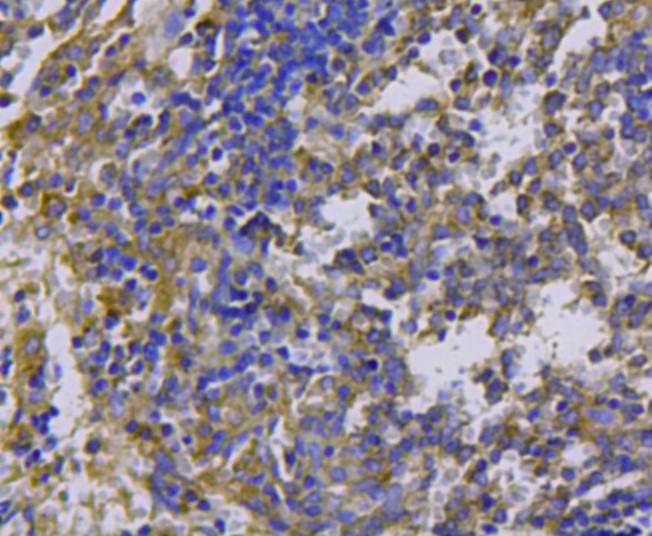
ER40501_6.jpg

cMet Rabbit Polyclonal Antibody

cat.: ER40501
| Product Type: | Rabbit polyclonal IgG, primary antibodies |
|---|---|
| Species reactivity: | Human, Mouse, Rat |
| Applications: | WB, IF-Cell, IHC-P, FC |
| Clonality: | Polyclonal |
| Form: | Liquid |
| Storage condition: | Shipped at 4℃. Store at +4℃ short term (1-2 weeks). It is recommended to aliquot into single-use upon delivery. Store at -20℃ long term. |
| Storage buffer: | 1*PBS (pH7.4), 0.2% BSA, 40% Glycerol. Preservative: 0.05% Sodium Azide. |
| Concentration: | 1ug/ul |
| Purification: | Immunogen affinity purified. |
| Molecular weight: | Predicted band size: 156 kDa |
| Isotype: | IgG |
| Immunogen: | Synthetic peptide within human Met aa 1350-1390. |
| Positive control: | Mouse liver tissue lysate, Mouse kidney tissue lysate, D3 cell lysate, MEF cell lysate, N2A, Hela, HepG2, mouse liver tissue, mouse spleen tissue. |
| Subcellular location: | Secreted, membrane. |
| Recommended Dilutions:
WB IF-Cell IHC-P FC |
1:1,000 1:200 1:200 1:100-1:200 |
| Uniprot #: | SwissProt: P08581 Human | P16056 Mouse | P97523 Rat |
| Alternative names: | AUTS9 c met D249 Hepatocyte growth factor receptor HGF HGF receptor HGF/SF receptor HGFR MET Met proto oncogene tyrosine kinase MET proto oncogene, receptor tyrosine kinase Met proto-oncogene (hepatocyte growth factor receptor) Met proto-oncogene Met protooncogene MET_HUMAN Oncogene MET Par4 Proto-oncogene c-Met RCCP2 Scatter factor receptor SF receptor Tyrosine-protein kinase Met |
Images

|
Fig1:
Western blot analysis of cMet on different cell lysates using anti-cMet antibody at 1/1,000 dilution. Positive control: Lane 1: Mouse liver tissue lysate Lane 2: Mouse kidney tissue lysate Lane 3: D3 cell lysate Lane 4: MEF cell lysate |

|
Fig2: ICC staining cMet in N2A cells (green). Cells were fixed in paraformaldehyde, permeabilised with 0.25% Triton X100/PBS. |

|
Fig3: ICC staining cMet in Hela cells (green). Cells were fixed in paraformaldehyde, permeabilised with 0.25% Triton X100/PBS. |

|
Fig4: ICC staining cMet in HepG2 cells (green). Cells were fixed in paraformaldehyde, permeabilised with 0.25% Triton X100/PBS. |

|
Fig5: Immunohistochemical analysis of paraffin-embedded mouse liver tissue using anti-cMet antibody. Counter stained with hematoxylin. |
|
Fig6: Immunohistochemical analysis of paraffin-embedded mouse spleen tissue using anti-cMet antibody. Counter stained with hematoxylin. |

|
Fig7: Flow cytometric analysis of Hela cells with cMet antibody at 1/100 dilution (blue) compared with an unlabelled control (cells without incubation with primary antibody; red). Goat anti rabbit IgG (FITC) was used as the secondary antibody. |
Note: All products are “FOR RESEARCH USE ONLY AND ARE NOT INTENDED FOR DIAGNOSTIC OR THERAPEUTIC USE”.